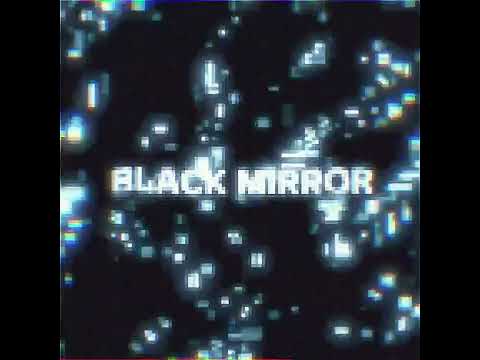
YouTube thumbnail

«Black Mirror»: Ανακοινώθηκε το πρώτο καστ της έβδομης σεζόν
Η σκοτεινά σατιρική ανθολογία του Τσάρλι Μπρούκερ επιστρέφει και το μέχρι τώρα καστ της μας κάνει να την περιμένουμε με αγωνία.
Το «Black Mirror» αποκάλυψε το πολλά υποσχόμενο καστ της 7ης σεζόν με τους Ακουαφίνα («Jackpot!»), Μιλάνκα Μπρουκς («Mum And I Don’t Talk Anymore»), Πίτερ Καπάλντι («Criminal Record»), Έμα Κόριν («The Crown», «Murder at the End of the World», «Deadpool & Wolverine»), την Ρασίντα Τζόουνς («Sunny»), Πάτσι Φεράν («Firebrand»), τον υποψήφιο για Όσκαρ Πολ Τζιαμάτι («Τα Παιδιά του Χειμώνα») , Λιούις Γκρίμπεν («Blade Runner 2099»), Όσι Ικίλε, Ρασίντα Τζόουνς, Σιένα Κέλι, Μπίλι Μαγκνούσεν, Ρόζι ΜακΓιούεν, Κριστίν Μιλότι (που συμμετέχει στο πολυαναμενόμενο «The Penguin») , Κρις Ο’ Ντάουντ («Bridesmaids)» , Ίσα Ρέι («Insecure», «Barbie») , Πολ Τζ. Ρέιμοντ («Horrible Histories») , Τρέισι Έλις Ρος και Χάριετ Γουόλτερ.
Περαιτέρω λεπτομέρειες σχετικά με τους χαρακτήρες που θα υποδυθούν οι ηθοποιοί δεν έχουν γίνει γνωστές, καθώς η παραγωγή του «Black Mirror» βρίσκεται σε εξέλιξη. Η σκοτεινά σατιρική ανθολογία του Τσάρλι Μπρούκερ θα επιστρέψει το 2025 με έξι νέα επεισόδια, συμπεριλαμβανομένης της συνέχειας της περιπέτειας επιστημονικής φαντασίας USS Callister, ένα από τα πιο δημοφιλή επεισόδια της σειράς.
‘Netflix’s ‘Black Mirror’ Sets Season 7 Cast With 19 Including Issa Rae, Paul Giamatti, Harriet Walter & Awkwafina https://t.co/B34pHOQyQu
— Deadline (@DEADLINE) September 19, 2024
Οι Τζέσι Πλέμονς, Κριστίν Μιλότι, Τζίμι Σίμπσον και Μικαέλα Κόελ πρωταγωνιστούν στο αρχικό επεισόδιο που προβλήθηκε ως πρώτο της 4ης σεζόν. Το βραβευμένο με Emmy επεισόδιο γράφτηκε από τον Μπρούκερ και σκηνοθετήθηκε από τον Τόμπι Χέινς. «Το USS Callister θα επιστρέψει… Ο Ρόμπερτ Ντέιλι είναι νεκρός, αλλά για το πλήρωμα του USS Callister, τα προβλήματά τους μόλις αρχίζουν», αναφέρεται σε ένα teaser που κυκλοφόρησε από το Netflix σε εκδήλωση στο Λονδίνο τον Μάρτιο- σύμφωνα με τον τελευταίο.
Ο Μπρούκερ δημιούργησε τη σειρά και είναι εκτελεστικός παραγωγός μαζί με την Τζέσικα Ρόουντς και την Άναμπελ Τζόουνς.
- Για τρίτη ημέρα στους δρόμους οι οδηγοί ταξί στην Αττική – Επέστρεψαν μέχρι νεοτέρας στην περιφέρεια
- Χαμός στους Μπακς με Αντετοκούνμπο: Μεγάλη διαφωνία για την επιστροφή του στα παρκέ (pic)
- Πολιορκία xωρίς τέλος, αντοχή χωρίς όρια: Όταν η αμερικανική μέγγενη συναντά τις κουβανικές ρίζες
- Σπειροειδής αποσταθεροποίηση – Ο Λίβανος μεταξύ πολέμου, φόβων νέου εμφυλίου και πλήρους κατάρρευσης
- Που «χάθηκε» ο Τζόζεφ Γκόρντον-Λέβιτ;
- Απολογείται ο 19χρονος φίλος του 20χρονου που δολοφονήθηκε στην Καλαμαριά – Αναζητείται ένα ακόμη άτομο
- Επενδύει στην εξωστρέφεια η περιφέρεια Στερεάς Ελλάδας
- Στον «πάγο» οι ρωσο-ουκρανικές συνομιλίες εν μέσω του πολέμου στο Ιράν
Ακολουθήστε το in.gr στο Google News και μάθετε πρώτοι όλες τις ειδήσεις








![Άκρως Ζωδιακό: Τα Do’s και Don’ts στα ζώδια σήμερα [Πέμπτη 19.03.2026]](https://www.in.gr/wp-content/uploads/2026/03/manouchehr-hejazi-QeoXkIesiCo-unsplash-1-315x220.jpg)














































































 Αριθμός Πιστοποίησης Μ.Η.Τ.232442
Αριθμός Πιστοποίησης Μ.Η.Τ.232442